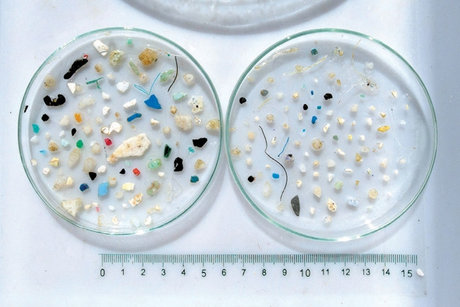

TARA
タラ号プロジェクトは、アニエスベーフランス本社のCOOであり、Tara Océan財団共同創設者兼会長であるエティエンヌ・ブルゴワが、アニエスベーと共に支援しているプロジェクトです。二人は2003年、科学的、環境保護的ミッションを遂行するためにスクーナー船を購入し、タラ号と名付けました。科学探査船タラ号は世界中を航海し、海が直面する環境的脅威や気候変化の影響を調査しています。
「私の愛するタラ号!
そう、このスクーナー船は、出会ってからずっと、私にとってかけがえのないもの。とても美しくて、とてもシンプル!船にあるものは全て無駄がなく美しいのです。タラ号の冒険や挑戦的な熱意を誇らしく、そして勇ましく思います。」
アニエスベー
TARA OCÉAN財団
Tara Océan財団(タラ オセアン財団)は、2003年より海洋環境問題を専門の科学者とともに調査する海洋科学探査船タラ号で気候変動と環境破壊が海洋にもたらす影響を研究しています。
See more…
これまでに北極、南極、太平洋、地中海などで温暖化、プランクトン、サンゴ礁、マイクロプラスチックなどをテーマとして12の探査プロジェクトを施行。世界60カ国、45万km以上を航海し、75の協力研究所や協力研究機関と共に21の科学研究分野にわたり、8万以上のサンプル採取や貴重なデータを収集しました。
日本国内にも2017年と2018年に、サンゴ礁を広範囲に網羅的に調べるタラ号太平洋プロジェクトの際、合計で約2ヶ月間寄港。小笠原諸島、福岡、尾道、神戸、名古屋、横浜、東京、下田、高知、沖縄などで海洋環境の講演やワークショップを数多く実施しました。
特に、2018年には香川県の三豊市に4日間滞在し市内の小学生全員を船に招待してワークショップを行い、未来を担う子供達への海洋環境教育に貢献しました。
2019年には、海洋環境問題を考えるワークショップと常設展示を行う拠点を瀬戸内海の粟島に作るため、香川県三豊市と連携協定を締結。日本におけるTara Océan財団の活動にも益々期待ができます。
海洋の未来を人類の未来と考え、今後直面することになる環境破壊の影響をさらに詳しく知ることは社会貢献に通じます。
そして、この現状を多くの人々に伝えるためにタラ号のクルーにはアーティストが乗船し、科学者が調べて解明して発信できることとは別に、アーティストでないと感じることができない海の状態、様子など、実際に海で体験したことを作品にして発表しています。芸術と科学の融合により未来を創り上げていくことは、アートにしかできない社会的な課題に対する問いかけが生まれるとともに、社会における新たなアートの役割、21世紀の社会に必要なアートの使命を提示し、22世紀へとつなぐためのプロジェクトといえます。
タラ オセアン ジャパン
日本の海は生物多様性に富む美しい海域ですが、珊瑚礁の白化や消失、磯焼け、酸性化などの問題が山積しており、海洋環境が危機に直面している事は他の海域と同様です。また、汚染物質のプラスチックが多く集まる”ホットスポット”ともいわれています。
日本の美しい海を守るため、そして、この世界規模の課題を、地域的なアクションから改善するべく、一般社団法人タラオセアンジャパンは、タラ オセアン財団の日本支部として設立されました。
See more…
2020年、タラ オセアン ジャパンは、全国の国立大学の臨海実験施設の連携組織“JAMBIO(マリンバイオ共同推進機構) ”と協力し、日本発のローカル科学プロジェクト、「Tara JAMBIO マイクロプラスチック共同調査(科学×アート×教育)」を立ち上げました。
このプロジェクトの目的は、大きく3つあります。
1.北は北海道から南は沖縄までの、日本列島の沿岸海域のマイクロプラスチック汚染の定量化とプラスチック汚染源の特定
2.プラスティスフィア(マイクロプラスチック粒子に付着する微生物叢)の研究。海洋生態系への影響を評価すること
3.マイクロプラスチックの現状のみならず、地球温暖化など人間活動が海洋に与える影響について、科学や、アート、教育の力を使って、こどもや若い世代、多くの方々に知っていただける機会を提供し、啓発活動を行う

タラ オセアン ジャパンのこれまでの成果
・2020年10月に始めたTara JAMBIOマイクロプラスチック共同調査では、日本沿岸の海域で表層水と海底の堆積物を採取し、マイクロプラスチック(5㎜以下のプラスチック)の汚染状況を調べました。これまでで最大規模の調査となります。
・2022年10月までに、北は北海道から南は、熊本県まで、13ヶ所の調査を行いましたが、既に観察、または処理済みの200個以上のサンプル(表層海水、海底堆積物、砂浜)の全てから、様々な種類のマイクロプラスチック(ポリマー、ポリスチレン片、マイクロファイバー等)が検出され、マイクロプラスチック汚染の広がりが改めて確認されました。
・調査・研究に加え、調査で訪れた各地では、海洋プラスチックの問題や、地球温暖化の海洋への影響を含めた、啓発イベントを、地元のこどもや大人へ向けて行いました。
今後は、全国マイクロプラスチックの長期のモニタリングを含めた海洋調査、研究の他、海洋保全の重要性の啓発、教育活動を、調査に同行したアーティストの作品展の開催などを、さらに積極的に進めていきます。
香川県三豊市との連携協定
瀬戸内海に浮かぶ「アートと環境の島」、粟島のある香川県三豊市は、海洋環境教育においてタラ オセアン ジャパンと連携協定を結んでいます。
タラ号が、2018年に三豊市の仁尾マリーナに寄港して以来、タラ オセアン ジャパンとの連携が続いています。
2021年までの取り組みはこちら
粟島は、海もあり、山もあり、自然豊かな美しい島です。
粟島は、3年に一度行われる、瀬戸内国際芸術祭の秋会期の舞台でもあり、アートも楽しめる島です。
若手芸術家を、数か月にわたり受入れ、島民も関わってアート作品を制作する、粟島芸術家村の活動もあります。
今年の瀬戸内国際芸術祭2022 秋会期には、その粟島芸術家村で、TARA展を行いました。
タラ号にも乗船したアーティスト、日比野克彦さん(現・東京藝術大学学長、タラ オセアン ジャパン理事)や、大小島真木さん、二コラ・フロックさんの作品の展示のほか、Tara JAMBIOマイクロプラスチック共同調査の中間報告を展示。
2022年4月には、タラ号ポスターコンクール2020と2021の優秀賞を受賞されたお子さんと保護者さまと一緒に、2022年9月にはタラ号ポスターコンクール2022の優秀賞を受賞されたお子さんと保護者さまと一緒に、粟島海洋環境クラブの合宿を行いました。粟島での、様々な活動を通して、海洋環境を守る事の重要性を感じて頂きました。
タラ号ポスターコンクール2022の粟島海洋環境クラブの合宿の様子はこちら
今後も、粟島海洋環境クラブ合宿を継続していく予定ですので、タラ号ポスターコンクールに、是非ご応募下さい。募集は、6月8日の世界海洋デー頃に発表する予定です。
HISTORY OF TARA
2003 | アニエスベーと、息子のエティエンヌ・ブルゴワが、海洋環境の脆弱性や重要性について研究し啓発する目的のために、フランスでタラ号海洋探査プロジェクトを発足。
See more…
2006-2008 |「タラ号 北極プロジェクト」ナンセンのフラム号遠征の113年後に、507日間にわたり北極海の氷上2600kmを漂流。国際極年というタイミングでもあった。
2009-2013 |「タラ号 海洋プロジェクト」過去最大規模のプランクトン生態系の調査と、地球規模の気候システムの中での役割を研究。100,000個の新種の海洋微生物の発見や、1億5千万以上の遺伝子発見につながった。
2014 |「タラ号 地中海プロジェクト」世界でも高密度なマイクロプラスチック汚染海域の一つである地中海で、7ヶ月の調査及び、その海洋生態系に与える影響の研究。
2016 | Tara Océan財団の日本の拠点として、一般社団法人TARA JAPANを創設
2016-2018 |「タラ号 太平洋プロジェクト」アジア太平洋地域にてサンゴ礁の大規模調査。気候変動に対するサンゴ礁の耐性について研究。日本へも2017年と2018年、寄港し合計で約2ヶ月間滞在。
2019 |「タラ号 マイクロプラスチック ミッション」海から陸へ。2019年5月より6ヶ月間、ヨーロッパの主要10河川を中心に、海洋プラスチックごみの発生源と、その影響を探査。
2019年9月3日 | TARA JAPAN と香川県三豊市が、環境教育と啓発活動の推進のために連携協定を締結。瀬戸内国際芸術祭2019秋会期に、粟島でTARA展を共催した。
2020 |「第10回円空大賞受賞・展示」岐阜県美術館で行われた円空大賞展で、タラ号の活動記録や、関連アーティストの作品が展示された。
2020年1月29日 | Tara-Jambio マイクロプラスチック共同調査 ミッションを発表。全国の大学に所属する臨海実験所のネットワーク JAMBIO (マリンバイオ共同推進機構)と協力し、日本沿岸のマイクロプラスチックの調査を、2020年4月から始める。今回、タラ号は使用せず、臨海実験所の調査船を使用。
2020年6月8日 | 世界海洋デーに、一般社団法人TARA JAPANから一般社団法人タラオセアンジャパンに名称変更。活動の中心である、オセアン(フランス語で海洋)を名称の中心に据えた。
ご寄付のお願い
タラ号や、タラ オセアン ジャパンの活動は、皆様からのご寄付に支えられています。
私たちの活動にご賛同いただけましたら、ご支援をどうぞよろしくお願いいたします。
タラ号ポスターコンクール
日本の子ども達が地球環境や海についてより関心をもつきっかけになることを目指し、2020年から「タラ号ポスターコンクール」を夏に開催しています。子どもたち自身が問題を考え、解決のためにアクションが取れるという自信や、社会へ発信することの大切さややりがいを感じていただくことを目指しています。
優秀賞に選ばれた方は、香川県三豊市の粟島で行う「粟島海洋環境クラブ」合宿(1泊2日)にご招待しています。次回の開催をお楽しみに !
TARA PRODUCTS
アニエスベーでは、科学探査船タラ号とのコラボレーション商品を販売しています。
タラ号のシンボルカラーを配したり、ワッペンを施したり。ファッションを通じて、世界中の海が直面する環境的脅威や、気候変動による影響を考えるきっかけに。
商品の売上金は、アニエスベーの海洋保護活動の一環として、Tara Océan財団の日本での活動を支援するため、一般社団法人タラオセアンジャパンに全額寄付されます。
タラ号スニーカー - コレクターズ・エ ディション(150足限定)
タラ号のメインセイル(主帆)をアッパーに使用したスニーカー。
北極周航(2013年)、地中海プロジェクト(2014年)、太平洋プロジェクト(2016年~2018年)、ミッションマイクロプラスチック(2019年)を支え、130,000 Kmの海を渡ったセイルを使用しています!
スニーカーの内側には、クロムを使用した「なめし加工」をしていないクロムフリーのレザーを使用。ソールは天然ゴムから出来ています。
また、EU基準に則った公正な労働条件を保証し、ISO 14000規格(環境管理の国際規格)も取得しているポルトガルのポルトにある小さな家族経営の工場で生産されました。
こどもタラ新聞
アニエスベーとTara Océan財団では、タラ号の活動や海の環境問題をより理解してもらえるよう「こどもタラ新聞」を観閲、ダウンロードできるサイトを準備しております。
より多くの子供たちに楽しみながら気候変動や、海洋環境問題について知ってもらい、これらは自分たちに直接関わりのある問題でもあり解決のために子供たちにも出来る事があること、行動する事の大切さを理解してもらいたいと考えます。